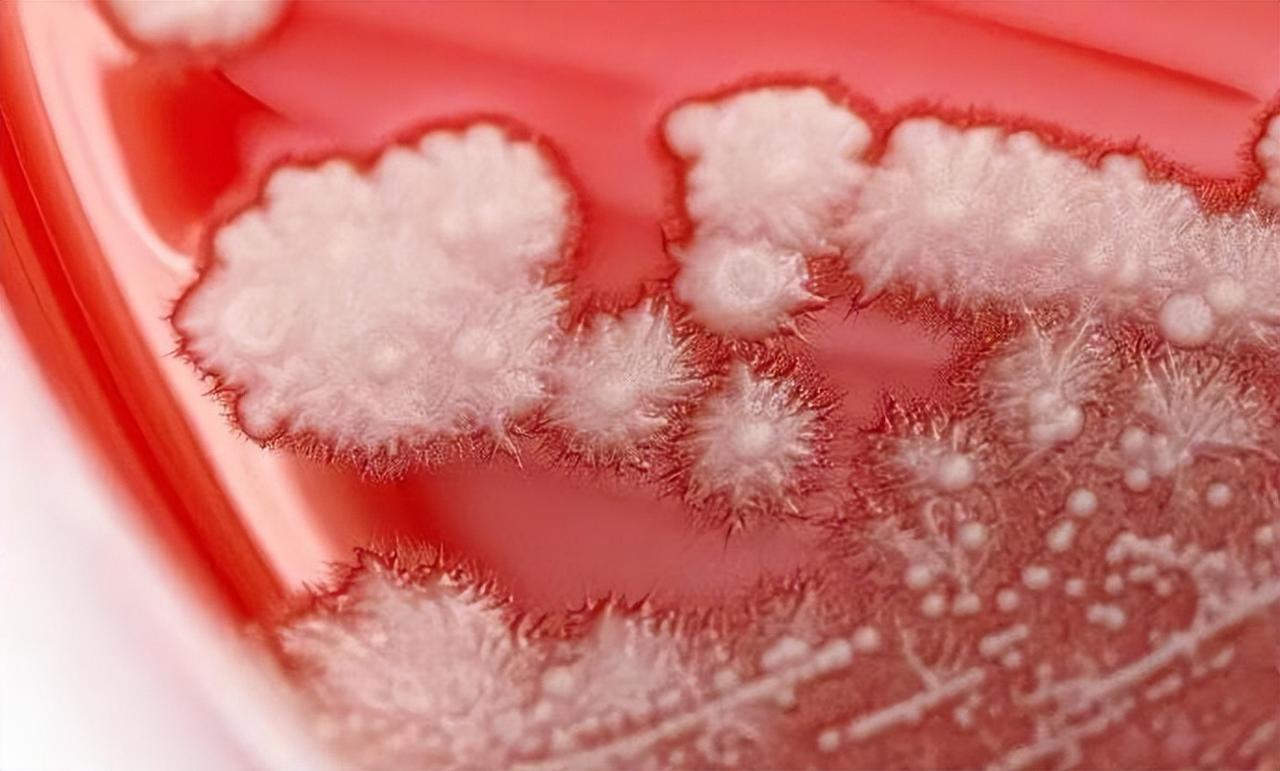

肝功能损害的风险,但多数病人不会出现严重的副反应,如果氟康唑耐药的话,则需要调整为伊曲康唑或者伏立康唑口服治疗。 这个真菌对于多数患者来说不会感染,普通人免疫力正常,真菌就很难侵入人体并产生增殖,甚至有一些感染者免疫力提升后自己也能好转, 但多数感染者的基础病不断消耗患者的免疫力,所以多数需要药物治疗才能好转。 白色念珠菌对生存环境和温度有一定的要求,这种病原体多数只会在口腔等浅表腔道生存,很少进入肺部导致肺部感染,深部内脏白色念珠菌感染常见于免疫力极度低下的情况,比如白血病化疗后或者骨髓移植后的病人。